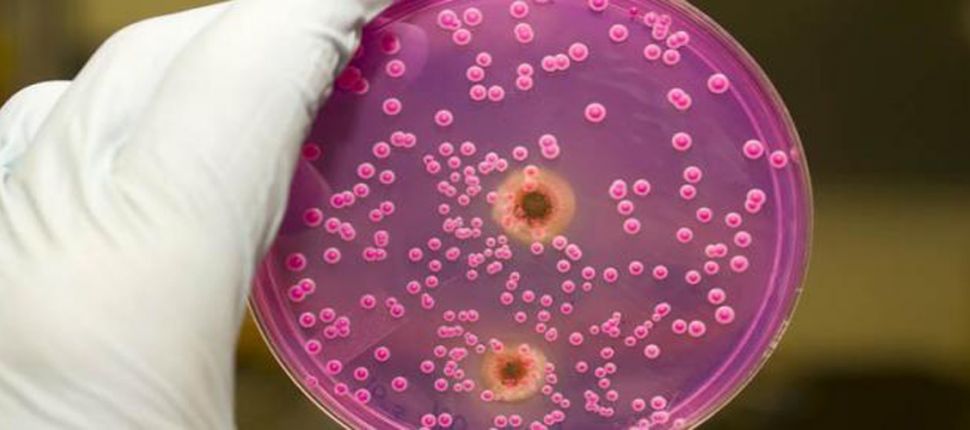

أمراض تفتك بمجتمعاتنا: الفطريات
حوار: جمانة عبد الساتر
أكثر من مئة ألف نوع من الفطريَّات يعيش على كوكبنا وكثير
منها يعيش على جلد الإنسان الذي يشكو من الإصابة بها خاصة في فصل الصيف. فما هي
أنواع هذه الفطريات؟ وما هي أسبابها؟ ومن هم الناس الأكثر عرضة للإصابة بها؟ وكيف
يمكن تفادي المخاطر الناجمة عن الفطريات الجلدية أو التخفيف منها؟ أسئلة شكّلت محور
المقابلة التي أجريناها مع الدكتور علي يحيى، الاختصاصي في الجراحة التنظيرية
والعامة والذي أراد التحدث عن موضوع الفطريات لأهميته.
* الفطريَّات وأنواعها
س: هناك العديد من الأشخاص الذين يشتكون من الفطريات خلال
فصل الصيف، برأيك ما هي أبرز هذه الأنواع التي تنتشر في مناطقنا؟
ج: إن الآفات الفطريّة التي تصيب الجلد أو الغشاء المخاطي، ليست من البكتيريا ولا
من الكائنات المتعدِّدة الخلايا إنَّما هي الطفيليات التي تنتشر على الجلد وتستفيد
منه وتعدي الأشخاص الآخرين. هناك الفطريَّات الجلدية التي تصيب فروة الرأس وتمنع
إنبات الشعر ضمن بقعة محدَّدة وتسمى باللغة العامية (الثعلبة)؛ وهي قبل أن تنتشر
تكون نقطة صغيرة وتمرّ بمراحل متعددة؛ بالإضافة إلى أنَّ قشرة الرأس تعتبر أيضاً من
الفطريات. أيضاً تنتشر الفطريات بين أصابع القدمين وخاصة عند الرياضيين لأنَّها
مرتبطة بالجهد والعرق والحرارة. كما أنَّ هناك نوعاً آخر في بلادنا والناس لا
تعيره كبير اهتمام وهو الفطريَّات في الأظافر الأمر الذي يسبّب سماكة غير عادية في
الظفر وتشققات وألواناً مختلفة ما يساعد على حصول التهابات بالإصبع وفي بعض الأحيان
خرّاجات.
* أسباب الإصابة بالفطريات
س: ما هي الأسباب أو العوامل التي تسبِّب الفطريات؟
ج: إنَّ من أهمِّ الأسباب اجتماع ثلاثة عناصر وهي الحرارة، الرطوبة، وعدم التهوئة.
وهذه العناصر متوفِّرة في بلادنا لأنَّ لبنان بلد حار ورطب. وهذه البيئة تعتبر
ملائمة لتكاثر الجراثيم وخاصَّة الفطريَّات؛ أضف إليها ظروف الحياة الاجتماعية فقد
تضطر المرأة أحياناً لوضع الحجاب فوق شعر رطب وسائق السيارة يضطر إلى القيادة طوال
النهار في جو من الحرارة والرطوبة، هاتان عينتان لحالات تتعرض باستمرار للإصابة
بالفطريات. أما في داخل المنزل فنجد المرأة يومياً تستعمل مواد كيماوية أثناء الجلي
أو مساحيق لتنظيف المنـزل ما يؤدِّي إلى فقدان الجلد للبصمات أحياناً وموت الجلد
وتكاثر الفطريات فوقه على مستوى اليدين والأظافر. كما لا بدَّ من الإشارة إلى
خطورة المأكولات المصنَّعة المعلَّبة، والبسكويت، أما الفرّوج الذي يحتاج في مرحلة
نموه من أربعة أشهر إلى خمسة أشهر ليصبح كبيراً نجده ينمو بسرعة خلال 40 يوماً
ويصبح جاهزاً للبيع بسبب الهرمون الذي يغذى به. كل ذلك يقلل مناعة أجسامنا، أضف إلى
ذلك أكل النشويات والسكَّريات والعصائر المحلاّة والمعجنات يسبب الإصابة
بالفطريَّات التي تربو على السكر لذا نلاحظ أنَّ مرضى السكري هم أكثر الناس إصابة
بالفطريَّات بالإضافة إلى الأشخاص الذين يتناولون السكريَّات بكثرة. تجدر الإشارة
إلى أنَّ الفطريَّات مثل السوسة التي تأكل الشجرة، تساعد على استنـزاف الجسم وتأخير
نشاطاته الحيوية، وعلى الشيخوخة المبكِّرة.
س: ماذا عن الفطريَّات التي تصيب الأغشية المخاطية داخل
الفم كالقالوع. وما هو الفرق بين القالوع و"الحمو" وما هي عوارضهما والأسباب
المؤدية إلى الإصابة بهما؟
ج: بالنسبة "للحمو" فإنَّه من الخطأ الشائع الاعتقاد أو الربط بينه وبين الحالة
النفسيَّة للمريض، لأنَّ أسبابه صحيَّة مرتبطة بمناعة الجسم وبوجود الفيروس المسبب
له. أمَّا القالوع فيصيب اللسان والغشاء الداخلي للفم وهو عبارة عن طبقة تسمى
الغشاء الكاذب ويكون لونه أبيض أو "غامقاً" ويصيب بالدرجة الأولى الأطفال الخدّج
حديثي الولادة المصابين بسوء التغذية أو الذين يتناولون الكثير من المضادَّات
الحيوية التي تخفِّف مناعة أجسامهم فتـزداد الفطريَّات لديهم. ومن الأسباب
التي تزيد القالوع رجوع أسيد المعدة، خاصَّة عند الأطفال حديثي الولادة والذين لم
يكتمل لديهم العضل بحيث يكون رأس المعدة رخواً وزلقاً، فبمجرد أن يأكل الشخص يزداد
أسيد المعدة ويرجع مع الطعام إلى الفم مسبباً بيئة حمضية أو حتى إذا لم يأكل وكان
نائماً بشكل أفقي يزحف الأسيد ويصعد فيكوي الحنجرة والفم. ولهذا فإنَّ الأطفال
حديثي الولادة هم الأكثر عرضة للإصابة بالالتهابات في الفم والأنف والحنجرة.
إن أحد أسباب رجوع الأسيد اضطراب الأمعاء ليس عند الطفل فحسب بل عند الكبار من
الجنسين. فالتلبك في الأمعاء يسبب ركوداً في أسيد المعدة ورجوعه نحو الحنجرة والفم
ما يسبب القالوع أو الفطريات خاصة على اللسان.
س: هل هناك أطعمة تـزيد الحالة تفاقماً؟
ج: نعم، لكن في حال كان هناك استعداد تكويني في الأمعاء، فالأغذية الغنية بالمواد
المتخمِّرة والغنية بالصلصات والبهارات والزيوت تساهم في زيادة المشاكل أيضاً،
بالإضافة إلى تناول المعجنات بكثرة والتدخين الذي يزيد أسيد المعدة مباشرةً. كما أن
قلّة مناعة الإنسان الناتجة عن الإصابة بالسرطان في أي مكان من الجسم تؤدي إلى ظهور
القالوع. وهذا يكون ذا طبيعة مختلفة في جسم منهك.
* الالتهابات الفطرية عند الفتيات
س: تكثر في هذه الأيام إصابة الفتيات الشابات بالالتهابات الفطرية فما السبب؟
الفطريات عبارة عن لمخة بنية أو داكنة عند الفتيات وهي مؤشر على وجود الفطريات
والتي من أسبابها وجود البيئة الحارة والرطبة الملائمة لانتشار العدوى في لبنان.
واللافت للنظر اليوم، إصابة الفتاة بسهولة بالفطريات حتى لو كانت بعمر الرضاعة. أما
الشائع فهو وجود الفطريات عند الفتاة المراهقة التي بلغت والتي لا توفر لها مدرستها
النظافة السليمة، ما يعني أنها تبقى حوالي 6 أو سبع ساعات بنفس الظروف غير الصحية
في جو من الحرارة والرطوبة.
س: الالتهابات النسائية البولية المزمنة هو أمر شائع له
عوارضه، ما هي أبرز العوارض؟
ج: تتمثل العوارض في ألم القدمين واليدين، "دوخة" في الرأس وعدم تركيز في العين،
وألم العضلات.بعض الفتيات يزداد وزنهن لاعتقادهن أنه بسبب تناولهن الوجبات السريعة
والسكريات. السبب هو النقص في وجود العضل والأنسجة والفيتامين (د) بسبب عدم تعرضهن
للشمس، حتى أن ترقق العظام بدايته تكون بعمر المراهقة والذي يحتاج إلى الكثير من
الفيتامينات والمواد الضرورية لبناء العظام والعضل لهذا يصبح جسدها حساساً وخاوياً
ومناعته محدودة. أما الفطريات التي تصيب مناطق ثنيات الجسم عند المرأة
البدينة فإن وجودها المتكرر مرتبط بالدرجة الأولى بالغذاء الغني بالسكر أو إذا كانت
مصابة بالسكري، لأن هناك ارتباطاً وثيقاً بين الفطريات ومرض السكري. والأهم هو
اكتشاف هذا المرض، معالجته وإلغاؤه.
* سبل الوقاية
س: استعرضنا أنواع وأسباب الفطريات، ما هي سبل الوقاية؟
ج: الوقاية الصحية هي الأساس والتي يجب أن تتضمن تنظيم الطعام والشراب أي تخفيف
السكريات والعصير والمعجنات والمواد الحادة التي تسبب تخمراً حاداً، وتقليل المواد
المصنعة، الامتناع عن الدخان و"النرجيلة" والغليون، تهوئة الجسد ككل وتجفيفه بعد
الحمام، عدم لبس الثياب مباشرة والاقتصار على ألبسة قطنية، عدم ارتداء الحجاب
والشعر مبلل، أو ارتداء الجوارب والقدمان مبللتان، لبس حذاء مريح، (كما يجب على
الرياضيين أن يتجنبوا الأحذية البلاستيكية)، عدم الجلوس مباشرة على كرسي بلاستيك
لفترة طويلة، وإذا أمكن أن نضع على الكرسي كنـزة أو منشفة أو وسادة خاصة يكون أفضل.
كذلك الأمر بالنسبة لسائق السيارة والعامل على الكومبيوتر، أضف إلى ذلك التقليل من
تناول المضادات الحيوية. العناية بالفم والأسنان بالسواك، عدم استعمال أغراض
الآخرين، وضرورة التنبه في المساجد إلى تكرير مياه البرك الموجودة فيها وتغييرها.
س: يكثر في الآونة الأخيرة الحديث عن لقاح لسرطان عنق
الرحم، ما هي فائدته وضرره؟
بالنسبة لسرطان عنق الرحم واللقاح الذي يجري الترويج له بإعطائه للفتاة في سن
المراهقة، إحصائياً أثبتت الدارسات انتشار هذا المرض في الغرب بسبب الاستهتار
بالعلاقات الجنسية. أما في بلادنا فهذه النسبة متدنية جرّاء احترام العلاقات، ونحن
غير معنيين بهذا اللقاح كونه يشكل أهمية محدودة.














